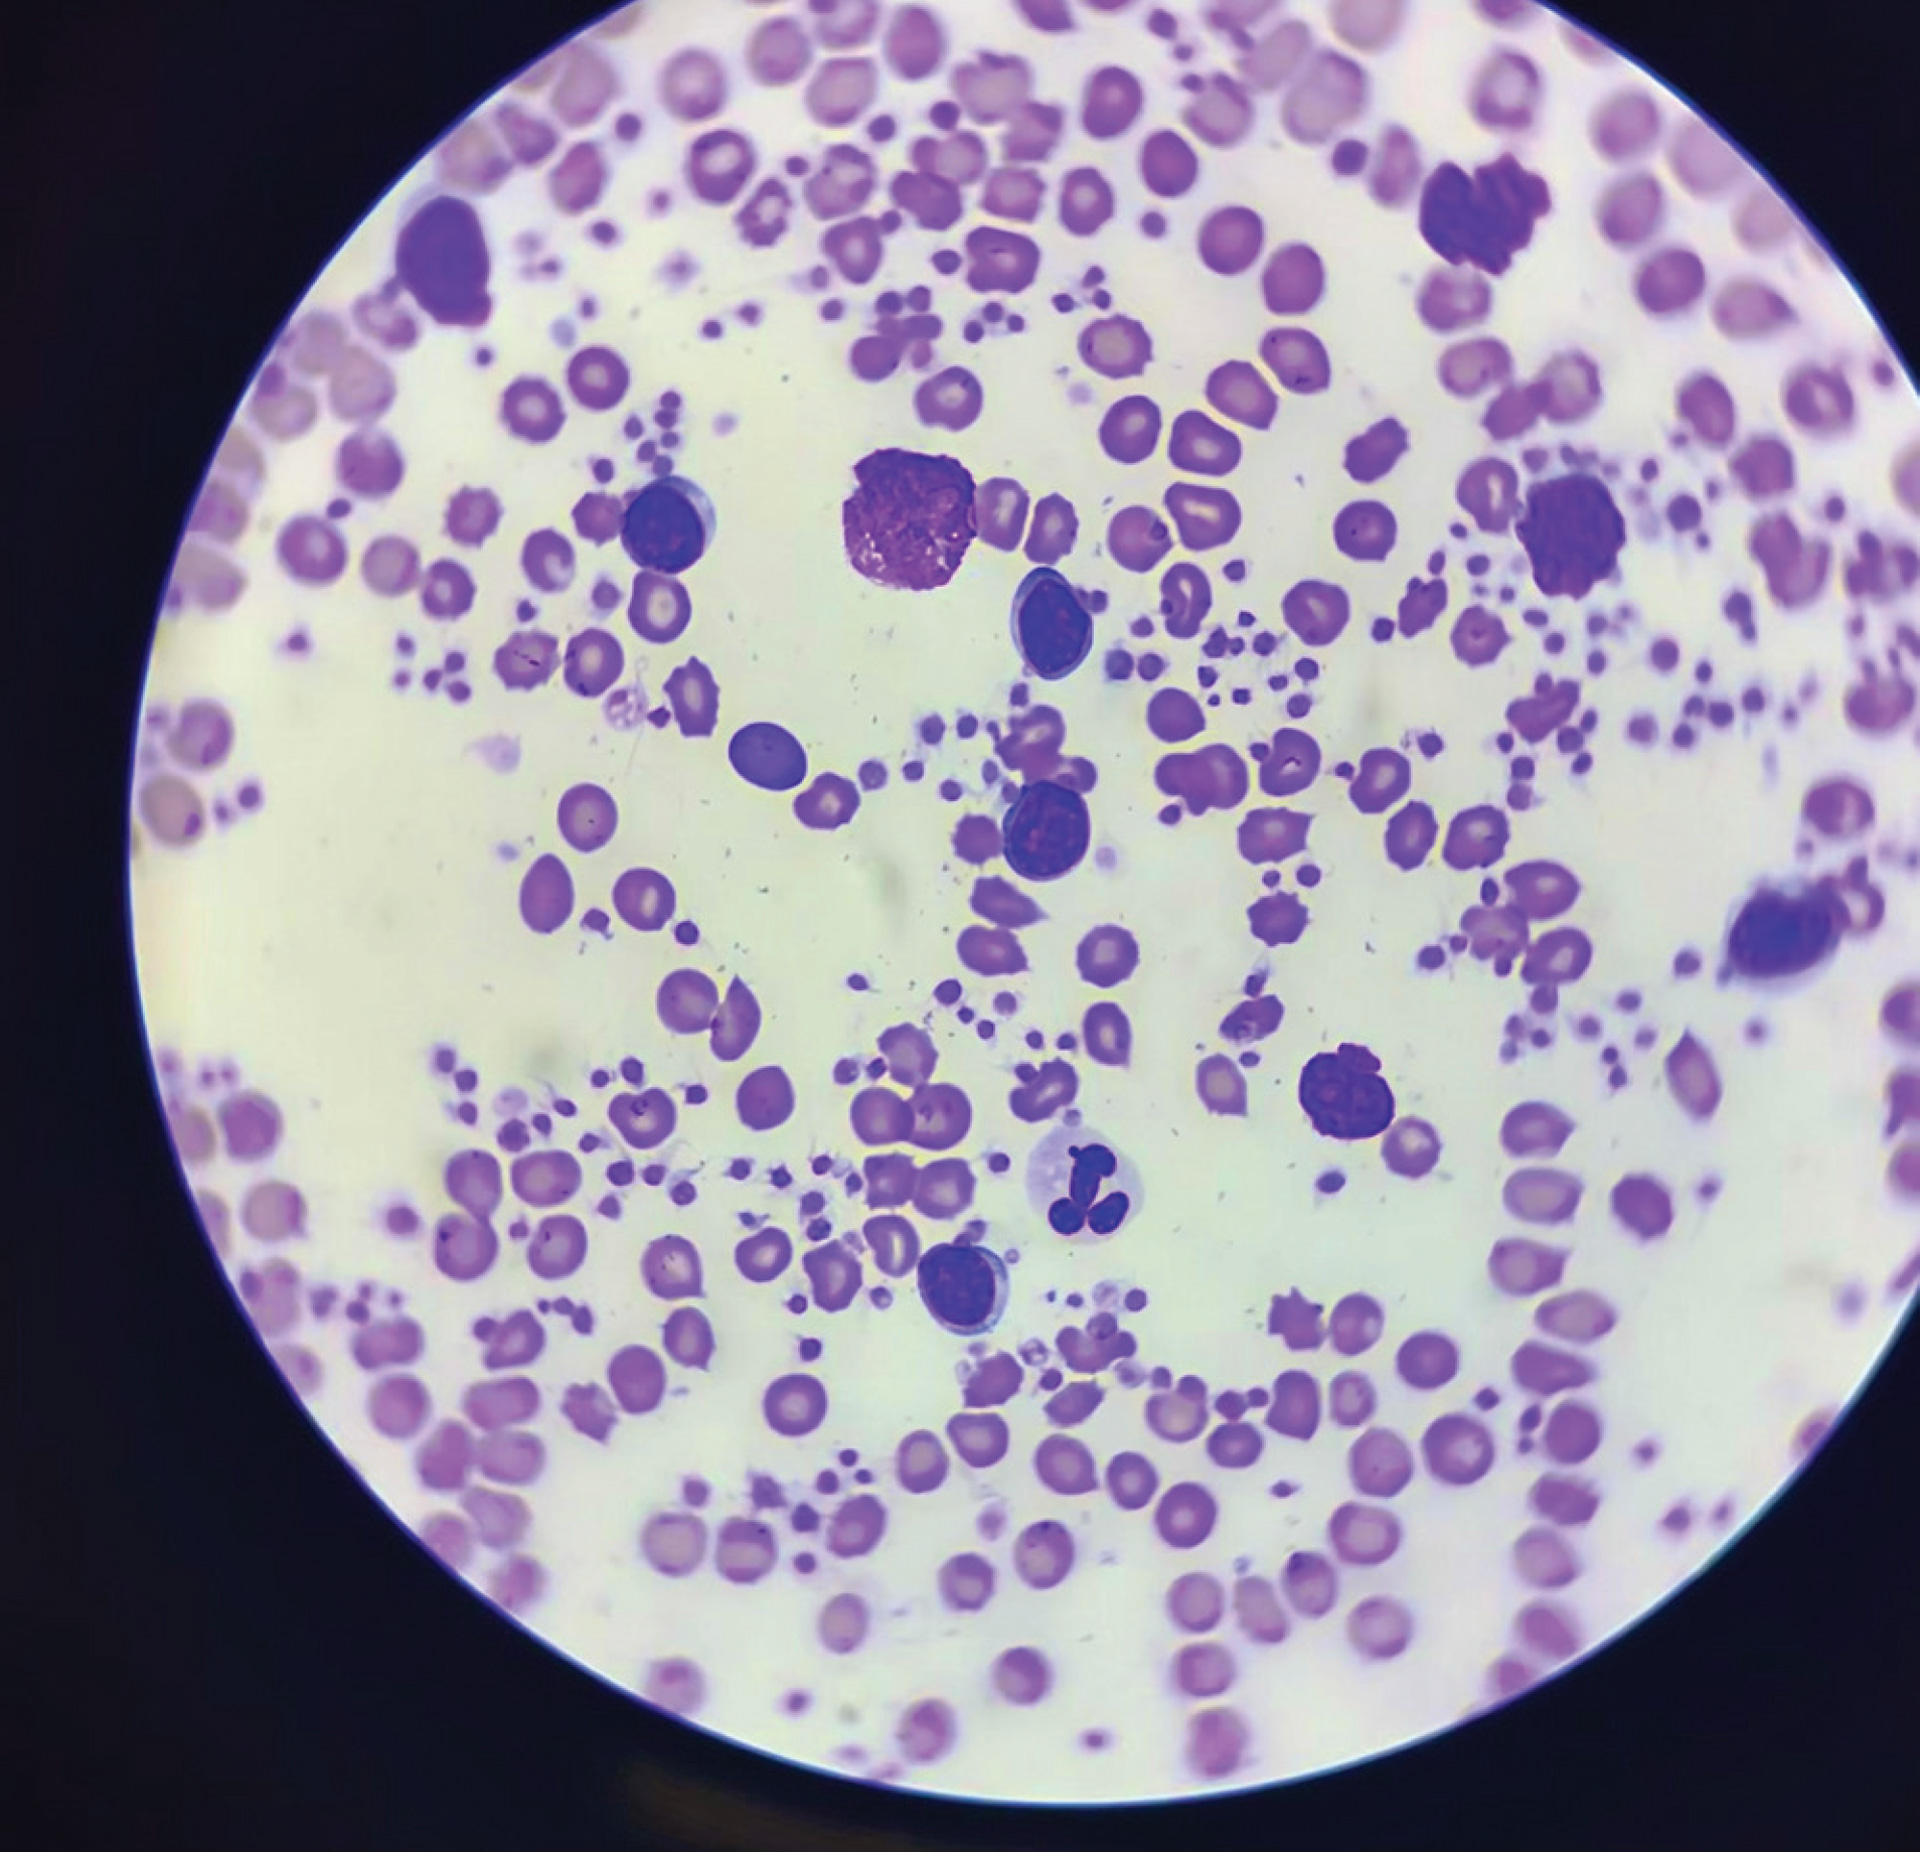

Diagnosing and treating canine lymphoma
The approach to diagnosing and managing a tumour can be daunting but once a diagnosis is made there are many treatment options available. A common tumour seen in general practice and referred to UCD Veterinary Hospital is canine lymphoma. Amy M Koterbay BVMS, MS, DACVIM (Oncology) clinical lecturer in Oncology, University College Dublin Veterinary Teaching Hospital, discusses the approach to diagnosing and treating this common tumour
Lymphoma is a proliferation of neoplastic lymphoid cells that responds well to chemotherapy. It most commonly occurs in the lymph nodes, but it can occur in other organs as well. Staging and phenotype help determine the most appropriate treatment type. Other factors including client’s finances and the patient’s demeanour and overall health need to be considered when determining the best treatment plan for a patient. The protocol is planned to ensure that this patient has the best quality of life for as long possible based on their individual needs.
When we see the diagnosis of cancer our first thought is that it is a death sentence for our patient. However, there have been many advances in veterinary oncology over the last decade. It can be daunting when trying to figure out the best way to get a diagnosis and, once we have that diagnosis, how do we communicate this to the client?
First, it should be noted that the same neoplasia diagnosis in dogs can have very different treatment options and outcomes than in cats. We treat more canines than felines in Ireland so this article will focus on the approach to a tumour in dogs.
A thorough history
How do we approach a tumour? First, we need to get a thorough history. Some important questions to ask when getting that history are:
- When did the owner first see the mass?
- Has it increased in size?
- Does the mass change in size and shape?
- Have you noticed any change in behaviour?
Asking questions to see if a pet is painful is also extremely important. If there is a mass on the abdomen, ask if s/he still allows the client to pet him/her? Will the patient lie on that side? Does s/he sleep through the night? Are they restless? It’s difficult to assess pain in a veterinary patient and it’s important to not ask the owner directly if the pet is painful. It’s not uncommon for an owner to say their pet is not painful but then when you do a physical examination, the patient is lame or showing other obvious signs of pain/discomfort.

Enlarged submandibular LN in a boxer.
Once you have a thorough history, the next step is to get a sample. The best first step and least invasive way to get a diagnosis is to do a fine needle aspirate (FNA) and send it in for cytology review. Some tumours will exfoliate easier than others but, with good technique, you can get a diagnosis with an FNA and cytology. However, not all tumours can be diagnosed with an FNA and some may require a biopsy. And even with a biopsy, there is always a chance that you need to prepare the owner that you may not get a diagnosis.
There are many reasons for this, but one example is that, as a tumour grows, it can outgrow its blood supply and become necrotic. Sampling the necrotic and/or infected masses may not be diagnostic. Occasionally, multiple samples (cytology or biopsy) need to be taken in order to get a diagnosis and these samples may need to be taken with ultrasound or computer tomography (CT) assistance.
Once we have the results confirming a diagnosis of cancer, the hardest part is telling results to the owner. Usually, these pets are considered a part of the family and this is devastating news for them to hear. However, the good news is that there are many treatment options that include everything from palliative care to multi-modality treatment.
Staging the patient
To determine the best treatment plan we must stage the patient to assess the extent of the disease as well as assess their overall health. What does staging accomplish? Staging is to assess the size of the primary tumour and assess all lymph nodes for any involvement, as well as look for metastatic disease. The other benefit of staging the patient is to allow us to assess their overall health. These patients are often senior pets and have other health issues we may not be aware of (eg., kidney or cardiac diseases) as they have not been identified yet. These health issues may not require treatment, however, they may alter the treatment plan.
The recommended staging is dependent on the tumour type, eg., chest radiographs and abdominal ultrasound for lymphoma versus a CT with a soft tissue sarcoma. The cost of staging with abdominal ultrasound and thoracic radiographs is approximately €600 to €700, while staging with CT is approximately €1,200 to €1,500. If additional samples are needed, the cost could increase by €200 to €300.
Once staging has been performed, a treatment plan can be made. Oncologists take into account time constraints and owners’ financial and emotional needs to determine the best treatment plan for that patient. Every pet and every family have different concerns that need to be addressed. The plan needs to be catered to that patient and their family needs.
Blood smear of a dog with stage IV lymphoma. See circulating large (neoplastic) lymphocytes.
Types of lymphoma
One of the most common tumours you will see is lymphoma (LSA). The most common type of lymphoma that we see is high grade, B-cell, multi-centric lymphoma but there are many types of lymphoma and they are classified based on location, phenotype, and grade of the tumour. All of these factors play a role in the response we can expect to treatment.
Lymphoma can occur anywhere in the body, lymphocytes arise in lymphoid tissue and although the lymph node, spleen and bone marrow are the most common locations they can occur in any organ. The most common presentation is multi-centric and this occurs in about 80 per cent of all lymphoma cases but other common locations are mediastinal, cutaneous, liver and renal.

Haematology of LSA patient with large lymphocytes.
Immunophenotype determines the cell type of the tumour and a clonal population of cells supports a diagnosis of cancer. There are three phenotypes of lymphoma: B, T, and NK-cell lymphoma. B-cell is the most common phenotype and can occur in up to 80 per cent of LSA cases. T-cell occurs in about 20 per cent with NK-cell occurring rarely. Multi-centric B-cell, the most common phenotype, has the best prognosis – with treatment, the average survival time is one year.
There are three grades of lymphoma: large, intermediate, and small. There is a huge difference between treatment and prognosis between large and small. Although small cell lymphoma is often a T-cell phenotype, the prognosis with treatment is good, with a survival time of up to two years.
All of these factors play a role in the treatment and prognosis of lymphoma and this is the reason why we recommend staging a patient along with obtaining a thorough history before initiating treatment. Staging includes bloodwork (complete cell count and biochemistry), urinalysis, chest radiographs, and abdominal ultrasound.
The history may help identify some positive or negative prognostic indicators. Some negative prognostic indicators are clinical signs at presentation and a history of steroid use. Patients are often given steroids as a treatment for a variety of health issues and those that have been given steroids for two weeks or longer are at a higher risk of not having a complete response to treatment and, thus, a shorter survival time. The reason for this is still debated but resistance to additional drugs is well-documented.
Bloodwork will also help assess the patients’ health and potentially play a role in staging. For example, anaemia is a negative prognostic indicator. Circulating neoplastic cells would tell us the patient is stage IV or V, which is also a negative prognostic indicator.
Phenotyping
On physical examination, if any new masses are identified, a fine needle aspirate (FNA) and cytology may be done. In addition, phenotyping is recommended once the diagnosis of lymphoma is made. This can be achieved in a variety of ways: immunohistochemistry, which can only be performed on a biopsy, or immunocytochemistry and PARR. The other option to get phenotype is with flow cytometry. Each of these options has their pros and cons and we often base themethod of phenotyping on the patient’s needs and financial considerations.
Thoracic radiographs need to be three-view. The most common areas to find lymphoma in the thorax involves the lymph nodes (e.g., sternal), mediastinum, or interstitial lung. In addition, thoracic radiographs also allow the veterinarian to evaluate for any other abnormalities which may affect the treatment plan (eg., cardiac disease). Abdominal ultrasound is preferred as it is superior to abdominal radiographs in identifying a mass, enlarged lymph nodes, intestinal wall thickening, and masses in the spleen and/or liver. Abdominal ultrasound also allows us to evaluate other organs and assess the patient’s overall health.


Abdominal ultrasound highlighting LSA in the spleen.
Treatment options
Once staged, we can recommend an appropriate treatment plan. There are several treatment options available and they include everything from weekly treatments with the chemotherapy protocol CHOP to palliative care. Survival time ranges from approximately one year with CHOP to two to three months with palliative care. CHOP is still considered the gold standard of treatment for B-cell large cell LSA, with weekly or biweekly treatments with the following drugs: doxorubicin, cyclophosphamide, vincristine, and prednisolone. The frequency, cost, and/or other health issues may rule out CHOP as a possibility for some clients and pets. Treatment can last as long as six months, with cost ranging from €2,500 to €3,500. Several factors play a role in cost and length of treatment including the size of the patient, delays in treatment, and adverse events which require hospitalisation etc. Some of these can be planned for but there are occasional unplanned costs.
Other chemotherapy protocols, which may suit the client and pet’s needs better, are single agents’ doxorubicin, lomustine, and a new drug rabacfosadine (Tanovea). All of these are recommended to be given every three weeks. Phenotype and cost would be the biggest factors to take into consideration when recommending these three drugs.
Adverse events associated with treatment are uncommon but do occur. Most are managed well at home with medications and it is rare that a patient needs to be admitted for supportive care. Hospitalisation can last from 12 hours to seven days, although the latter is rare.
Life-threatening adverse events have been reported but they are extremely rare and in this author’s 10 years of experience, it has not been witnessed yet. The most common side effects we see as a result of chemotherapy are gastrointestinal and bone marrow suppression-related. Gastrointestinal (GI) signs can be due to the destruction of epithelial cells in the GI tract or stimulation of the vomiting centre in the CNS. Anti-nausea medications can be given as preventatives and are effective. Treatment of GI signs with medication usually sees an improvement of clinical signs within a couple of days. Bone marrow suppression is expected with chemotherapy. Each patient’s nadir is different depending on the individual drug with most nadirs occurring between seven and 14 days.
The importance of bloodwork
There’s an important balance to be struck between treating cancer appropriately and not putting the patient at risk of infection with the possibility of developing sepsis. This is why routine bloodwork is a requirement. Bloodwork typically costs about €50 which is an added expense but, by not performing bloodwork, you can put the patient at significant risk. Once the patient’s white blood cell count drops below 3,000 x 109 and/or the neutrophil count drops below 1,500 x 109, the risk of developing sepsis increases. Certain drugs like doxorubicin have a higher risk than other drugs, like lomustine, of causing sepsis. It’s important to understand the mechanism of action and potential side effects and risks of these drugs when administering.
A trained professional, whether it be a nurse or veterinarian, should be well-educated in the safety and handling of these drugs, as well as in the use of a closed system transfer device (CSTD). It is well-documented that exposure to these drugs can increase the risk to the administrator. Chemotherapy drugs usually have a low therapeutic index which increases the risk to the administrator and pet. Proper personal protection equipment (PPE) must be worn at all times and each administrator must be trained in the handling and disposing of these drugs.
Lymphoma treatment is not always straightforward but there are many treatment options that we can consider. Each patient has their own recommendations based on their needs and, once these are determined, we work with the client to determine the best plan to provide this patient with the best quality of life for as long as possible.
-
Avallone G, Rasotto R, Chambers JK, Miller AD, Behling-Kelly E, Monti P, Berlato D, Valenti P, Roccabianca P. Review of Histological Grading Systems in Veterinary Medicine. Vet Pathol. 2021 Mar 26
-
Benjamin SE, Sorenmo KU, Krick EL, Salah P, Walsh KA, Weinstein NM, Keuler NS, Avery AC, Atherton MJ, Lenz JA. Response-based modification of CHOP chemotherapy for canine B-cell lymphoma. Vet Comp Oncol. 2021 Mar 17
-
Hanot CC, Mealey KL, Fidel JL, Burke NS, White LA, Sellon RK. Development of prednisone resistance in naïve canine lymphoma: Longitudinal evaluation of NR3C1α, ABCB1, and 11β-HSD mRNA expression. J Vet Pharmacol Ther. 2020 Mar;43(2):231-236.
-
Miscellaneous Tumors, Editor(s): David M. Vail, Douglas H. Thamm, Julias M. Liptak, Withrow and MacEwen's Small Animal Clinical Oncology (Sixth Edition), W.B. Saunders, 2019, Pages 773-810, ISBN 978032359496, https://doi.org/10.1016/B978-0-323-59496-7.00034-7. (https://www.sciencedirect.com/science/article/pii/B9780323594967000347) Vail DM, Thamm D, Liptak, J. Small animal clinical oncology. Saunders 2020
-
Smith AN, Klahn S, Phillips B, Parshley L, Bennett P, Flory A, Calderon R. ACVIM small animal consensus statement on safe use of cytotoxic chemotherapeutics in veterinary practice. J Vet Intern Med. 2018 May;32(3):904-913. doi: 10.1111/jvim.15077. Epub 2018 Mar 30. PMID: 29603372; PMCID: PMC5980460.
1) What is the most common type of lymphoma?
A. B-cell multi-centric LSA
b. T-cell multi-centric lymphoma
c. T-cell cutaneous lymphoma
d. B-cell splenic lymphoma
2) What is the best way to diagnose phenotype?
A. Cytology
b. Biopsy
c. Flow cytometry
d. PARR
3) When do we typically see a chemotherapy nadir?
A. 5-10 days
b. 7-14 days
c. 24-48 hours
d. 14-21 days
4) Which one of the following is a common lymphoma location?
A. Cutaneous
b. Cardiac
c. Ocular
d. Thyroid
5) Once there is a diagnosis of lymphoma, phenotype is important to which of the following?
A. To determine prognosis
b. To arrange the best treatment plan
c. To determine expected quality of life
d. A and B
E. All of the above
Answers: 1 A; 2C; 3B; 4A; 5D.














